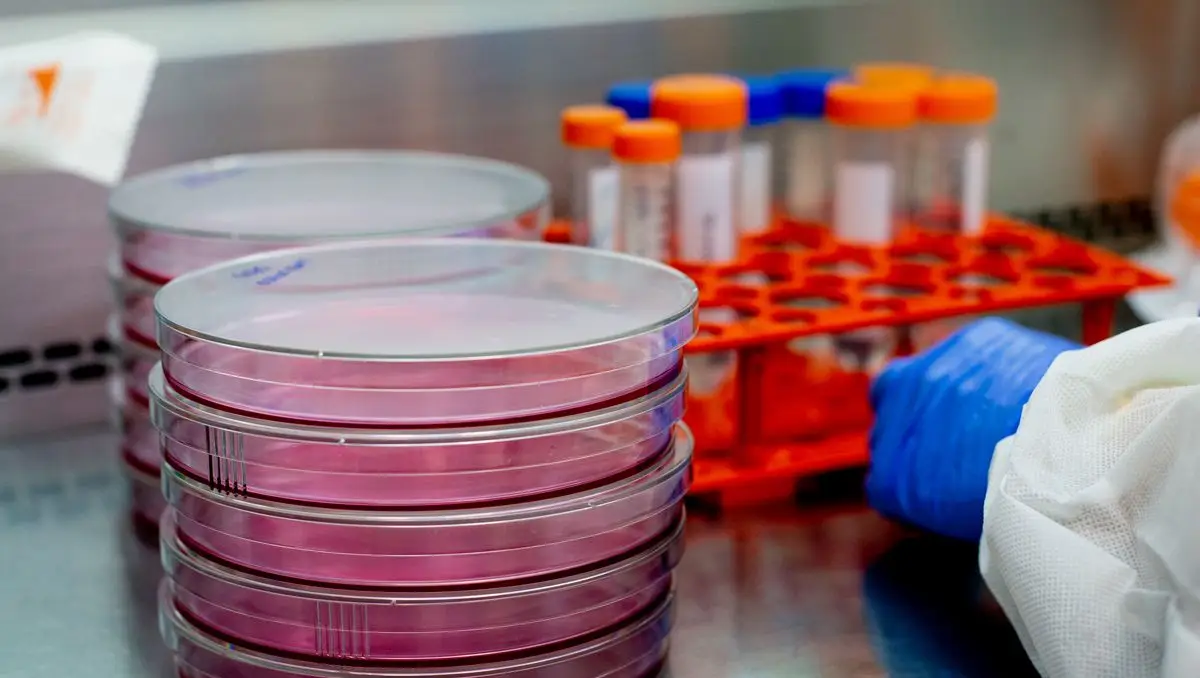

Foi detetado em Portugal o primeiro caso da nova variante do coronavírus identificada inicialmente na África do Sul, confirmou o Instituto Ricardo Jorge.
Os especialistas reforçam que, apesar do elevado potencial de transmissão, não há para já estudos que indiquem que esta variante seja mais perigosa que as outras ja conhecidas.
O sul-africano que mora em Lisboa terá chegado a Portugal pouco depois do Natal. A variante foi diagnosticada a 7 de janeiro.
As autoridades de saúde estão atentas a esta variante por causa do elevado potencial de transmissão
Estão a ser realizados estudos para perceber se esta variante é mais perigosa que as outras já identificadas.
Os especialistas realçam no entanto que faz parte do processo evolução do vírus surgirem variantes. Se for necessário, é sempre possível adaptar as vacinas.
A estirpe do Brasil ainda não foi confirmada em território nacional. Quanto à variante do Reino Unido, estima-se que Portugal já tenha cerca de 30 mil casos.
VEJA TAMBÉM:
- Primeiro caso de nova variante identificado em pessoa sul-africana residente em Portugal
- Origem do novo coronavírus "é um grande quebra-cabeças", diz OMS
- Variante britânica é mais mortífera além de mais contagiosa
As últimas notícias em https://sicnoticias.pt/ultimas